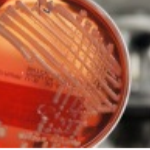

Our Dentistry
- (2021/04/21)生物学的幅径を回復できる処置を更新しました
- (2020/06/06)ソケットプリザベーションを更新しました
- (2020/06/04)咬座印象(コウザインショウ)を更新しました
- (2020/06/03)スプリットキャストを更新しました
- (2020/05/30)開放性仮封法(かいほうせいかふうほう)を更新しました
- (2020/04/20)パノラマ無名線を更新しました
- (2020/04/18)ターナー歯を更新しました
- (2020/04/16)歯肉溝内切開(シニクコウナイセッカイ)を更新しました
- (2018/07/29)アダムスクラスプを更新しました
- (2018/07/29)Calnanの3徴候を更新しました
- (2018/07/29)粘膜下口蓋裂(ネンマクカコウガイレツ)を更新しました
- (2018/07/29)ガードナー症候群を更新しました